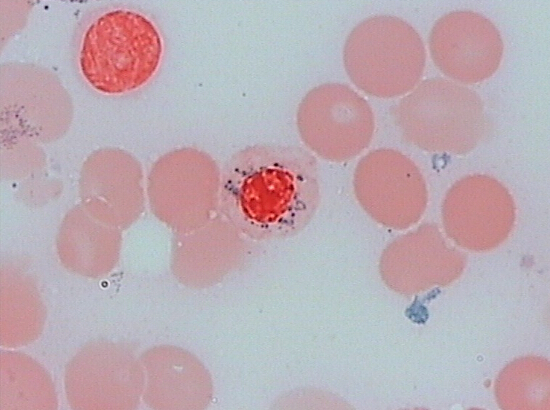
铁粒幼细胞
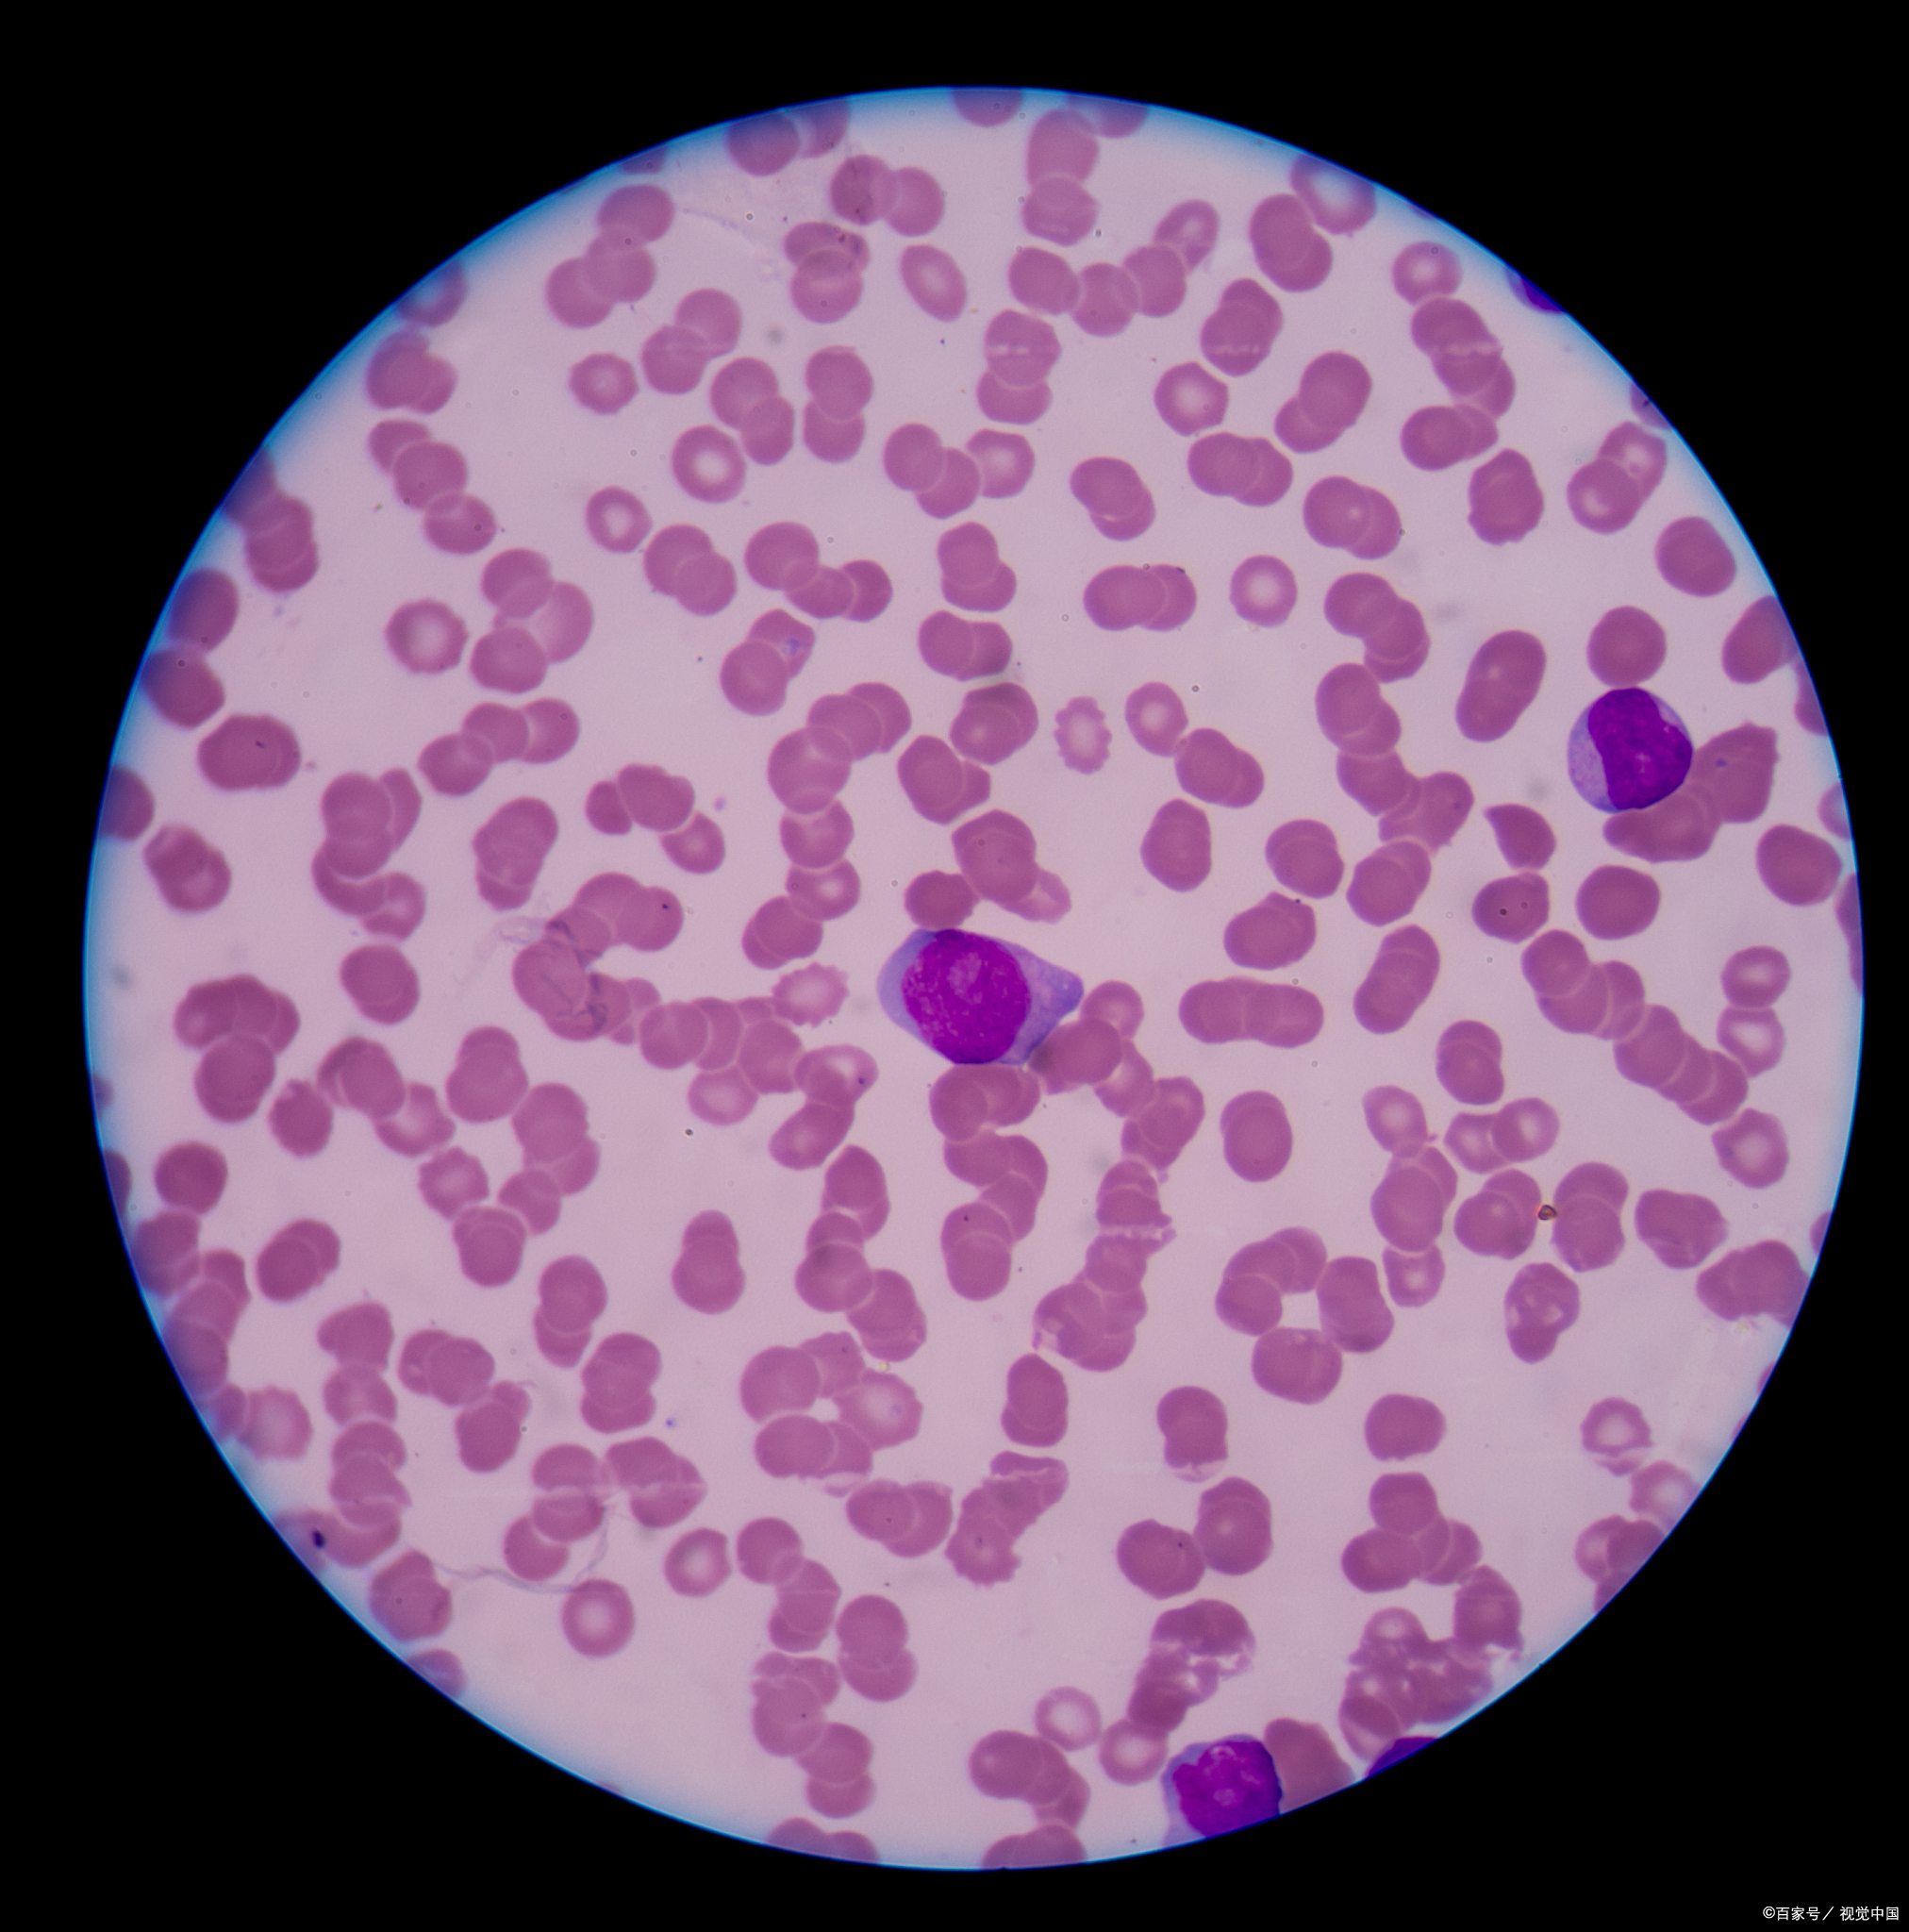
mds铁粒幼细胞贫血,"转白"风险到底有多大?
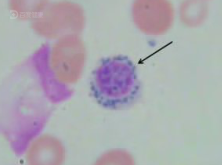
头晕乏力,食欲不佳确诊难治性贫血伴环状铁粒幼红细胞?
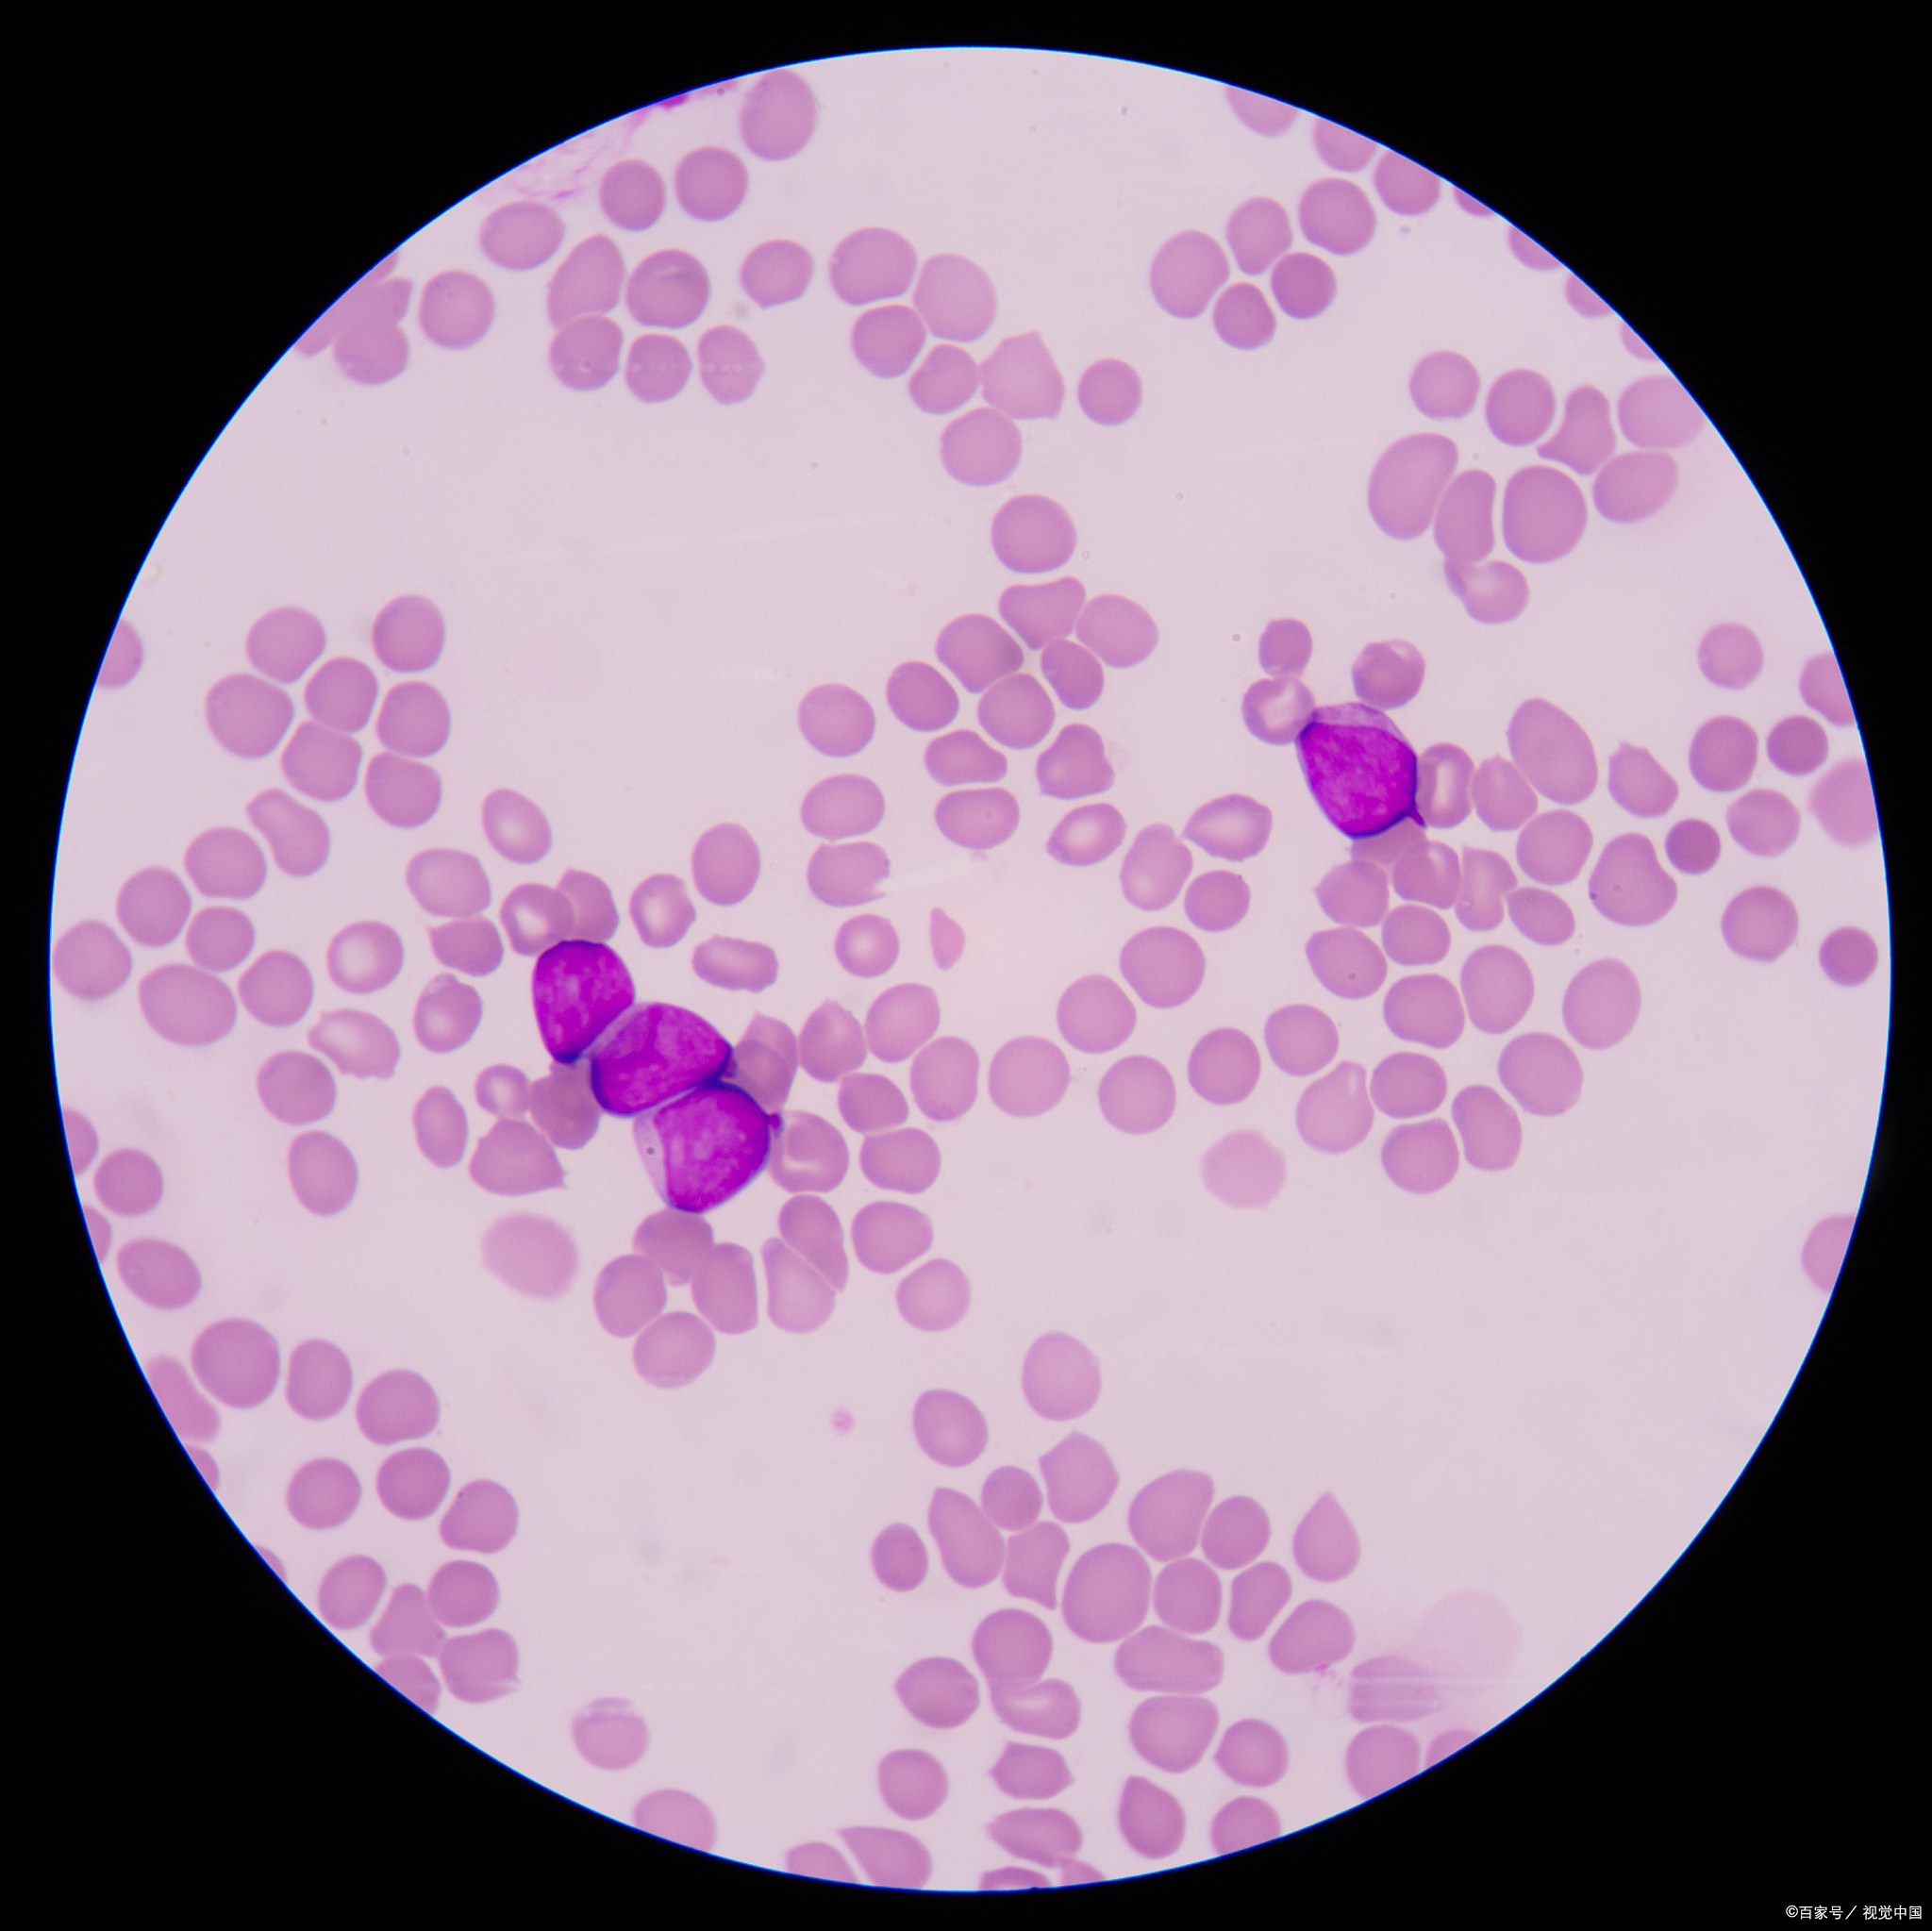
是一种骨髓造血功能衰竭性疾病,其主要表现为全血细胞减少
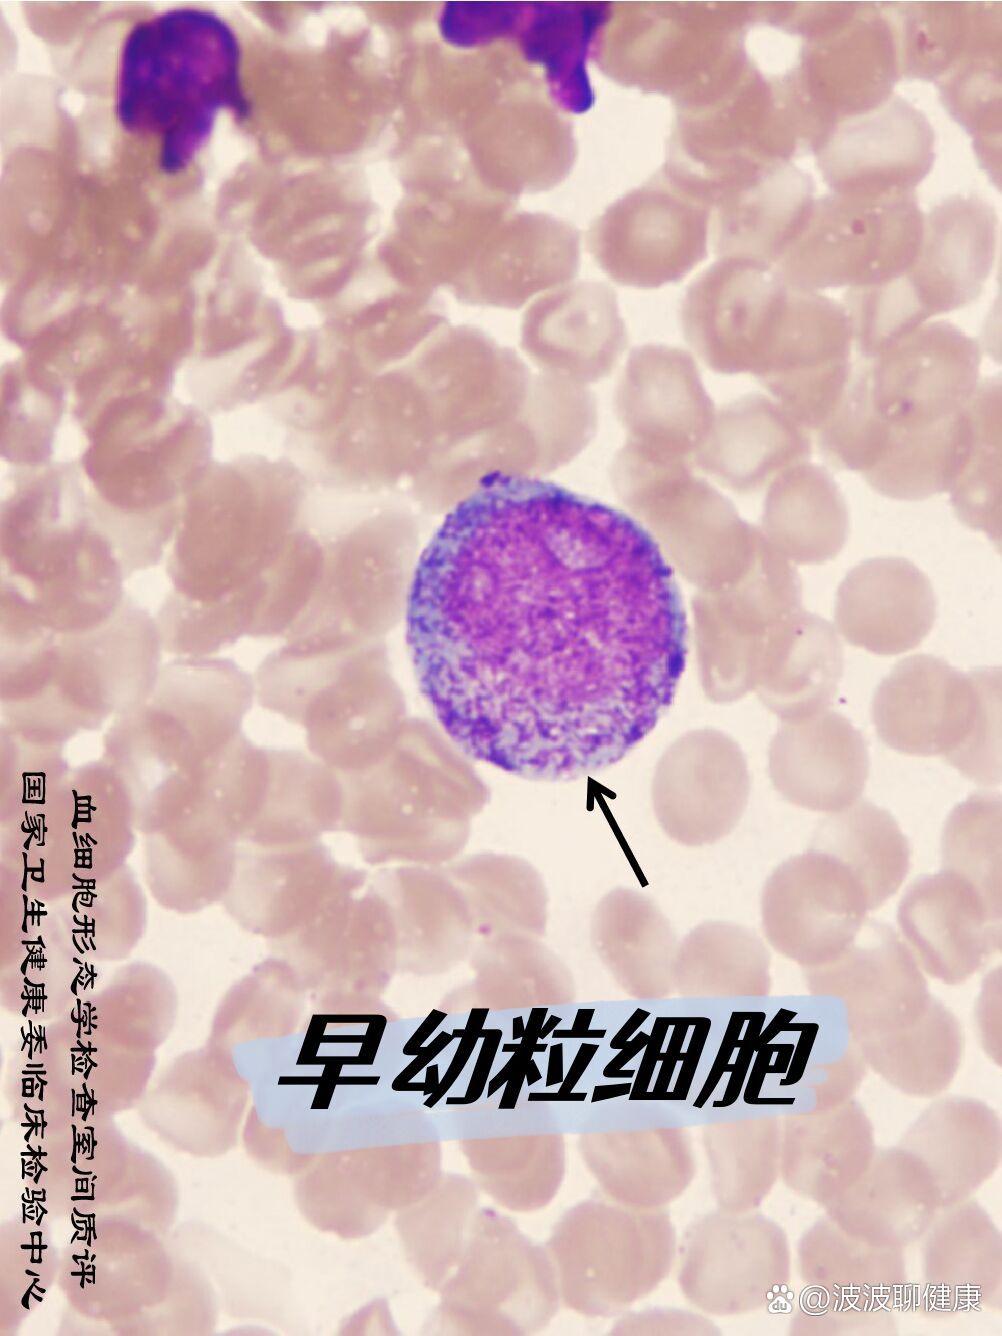
早幼粒细胞

铁粒幼细胞图片

铁粒幼细胞
图片尺寸550x410
铁粒幼细胞
图片尺寸550x410
铁粒幼细胞性贫血中的环状铁粒幼红细胞
图片尺寸500x335
铁粒幼细胞
图片尺寸550x410
mds铁粒幼细胞贫血,"转白"风险到底有多大?
图片尺寸2024x2048
继发性铁粒幼细胞性贫血
图片尺寸458x332
头晕乏力,食欲不佳确诊难治性贫血伴环状铁粒幼红细胞?
图片尺寸222x165
细胞外铁增多铁染色:花瓣核晚幼红巨幼变及核畸形红细胞,畸形核粒细胞
图片尺寸660x489
一例儿童遗传性铁粒幼细胞性贫血病例全程管理分享
图片尺寸678x275
铁粒幼细胞,环形铁粒幼细胞和铁粒红细胞
图片尺寸1020x765
🔬 细胞形态学:中幼粒细胞及以下阶段解析
图片尺寸2560x1809
细胞外铁增多铁染色:花瓣核晚幼红巨幼变及核畸形红细胞,畸形核粒细胞
图片尺寸660x475

一例铁粒幼细胞明显增多的贫血患者案例
图片尺寸459x268
是一种骨髓造血功能衰竭性疾病,其主要表现为全血细胞减少
图片尺寸2048x2047
缺铁性贫血是由于体内铁储备不足,无法满足正常红细胞生成的需要而
图片尺寸2048x2048
🔬 形态学探秘:中性杆状核粒细胞揭秘 🔬
图片尺寸1080x1033
教你认细胞2
图片尺寸1920x2532
粒细胞系统
图片尺寸1080x1139
早幼粒细胞
图片尺寸1002x1336